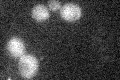
YHR087W
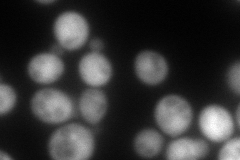
YHR087W
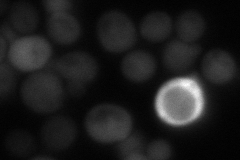
YHR087W

View description
Protein of unknown function involved in RNA metabolism; has structural similarity to SBDS, the human protein mutated in Shwachman-Diamond Syndrome (the yeast SBDS ortholog = SDO1); null mutation suppresses cdc13-1 temperature sensitivity
Localization:
Intensity:
Fold change:
Significance:
-
C’ GFP library in SD
below threshold15.49 -
N' NOP1pr-GFP in SD

cytosol178.193 -
N' TEF2pr-mCherry in SD
cytosol200.045 -
N' NATIVEpr-GFP in SD
cytosol75.5481 -
N' TEF2pr-VC and Cyto-VN in SD

cytosol69.7632 -
C’ GFP library in SD+DTT

cytosol15.931.02No -
C’ GFP library in SD+H2O2

cytosol17.061.1No -
C’ GFP library in Starvation Media

cytosol17.231.11No -
C’ GFP library on the background of Pup2-DaMP

below threshold -
C’ GFP library on the background of CCT mutant

below threshold15.92911.02797No
